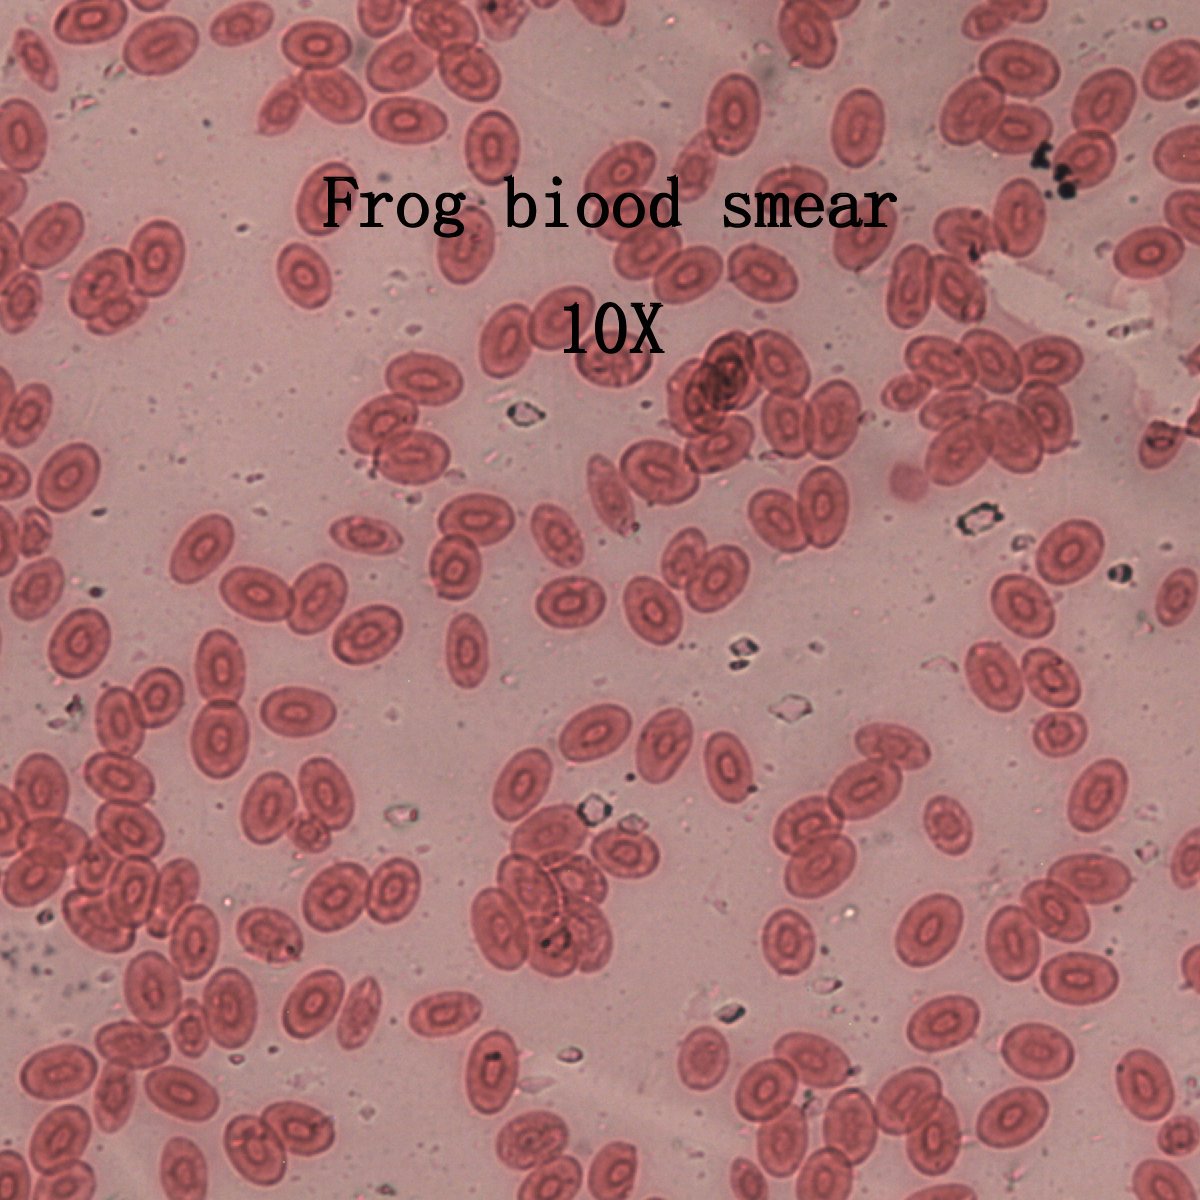

5 Prepared Microscope Slides Specimen Set, Plant and Animal Cells
 5 Prepared Microscope Slides Specimen Set, Plant and Animal Cells
5 Prepared Microscope Slides Specimen Set, Plant and Animal Cells

- A great starter set of 5 biology slides, including plant and animal specimen.
- Professionally prepared and stained glass slides.
- Individually labeled and numbered for easy referencing.
- Glass slide dimensions measure 1x3 inch (75x25mm).
- Ideal for education or teaching in high school, elementary school, or home school. A way to spark interest in science!
Plane Slide. Glass Slide Quantity per Pack: 5pc. Glass Slide Dimensions: 25.4x76.2mm (1x3 in. ). Cover Slip Shape: Round. Cover Slip Dimensions: Dia. 16mm. Cover Slip Thickness: 0.15mm.
Applications
Education & Student, College & Undergraduate, Compound (High Power) , Graduate & Research, High School (9-12)
We Offer World Wide Shipping (We are Based in California, USA)
Free Shipping within the Contiguous U.S.
We offer Free Economy Ground Shipping on all orders to U.S. contiguous locations placed on our website. When you select Free Shipping at checkout, we’ll ship your order with the most cost-effective shipping method. If you prefer a specific carrier, please select a paid shipping option instead of Free Shipping.
Note on Purchase Orders: Free shipping is only offered for orders placed online, and paid by Credit Card/Debit Card, or PayPal on our website. You may place your Purchase Order online, and enter your PO # in the Order Comments, and this PO# will show on your Packing Slip. Free shipping does not apply to Purchase Orders sent by email. If you are a company or university and emailing us a Purchase Order, the shipping fee will be added onto your invoice. Alternatively, you may provide a shipping account for us to ship the order under.
Free shipping does not apply to orders of any international and non-contiguous U.S. locations, such as Alaska, Hawaii, all off-shore U.S. territories and possessions, American Samoa, Guam, Northern Mariana Islands, Puerto Rico, and the U.S. Virgin Islands.
Expedited Shipping
We offer expedited shipping via FedEx and UPS.
For all expedited shipping services, such as Overnight, Next Day, etc - While we will do our part to ensure the packages are received by the shipping carriers to meet the shipping cut off times, please note that once the package leaves our warehouse, we are no longer responsible for the delivery of the package. The shipping carrier is responsible for delivering your package.
Shipping On Your Shipping AccountWe can ship your order on your own shipping account, if you are ordering for a business or organization and have a shipping account with FedEx or UPS.
- At Checkout, under Shipping Methods, select Ship on my account.
- Under "Order Comments" section, enter your: Carrier, Shipping Service, Account #, Zipcode, Add Insurance or No Insurance.
- For example: "Ship on our account using UPS 2nd Day Air AM, Acct #: 12345, Zipcode: 90024, Add Insurance."
- *Shipping Carrier Insurance insures the package through your shipping carrier on your account. If insurance instructions are not specified, we will automatically fully insure the package through the carrier.
Shipping Costs
If you select services other than "Free Shipping" during checkout, your order will be shipped per your selected shipping method, and the shipping fee will be added to your order/invoice. Shipping costs are provided by the shipping carriers and calculated based on shipping location, product dimensions and weight.
BoliOptics products are warranted against manufacturer’s defects in material and workmanship from the original date of purchase, for the following years:
Lifetime Warranty
Designated products marked lifetime warranty.
5 Year Warranty
Microscopes (except video and digital microscopes) come with a five (5) year factory warranty against manufacturing defects.
5/1 Year Warranty
Products with 5/1 Year Warranty means that the hardware of the microscope is under 5 year warranty, and the electrical and lighting components are under 1 year warranty.
1 Year Warranty
Includes video microscopes, digital microscopes, electrical and electronic products such as light sources, cameras, software, monitors, and electronic components.
Microscope accessories (such as microscope cameras and illuminators) come with a one (1) year warranty, except when specified in the description.
Warranty does not apply for consumable accessories and parts such as bulbs, batteries, fuses, cords, optical components or any add-on accessories such as mechanical specimen holders that are not built into the microscope stage as an integral part of the original manufacture, etc.
Warranty does not cover ordinary wear and tear or damage caused by improper use or accidents (drops).
Warranty does not cover products that have become inoperable due to lack of maintenance.
Warranty is void when products are disassembled, structural parts were opened up, removed, unscrewed, tampered with, or broken during use or in the user's possession.
Warranty is void when product QR Codes or Barcode Stickers containing the Product's Serial Number are removed from the product.
Customers are responsible for round-way shipping for warranty services.
BoliOptics Return Policy
BoliOptics offers a thirty (30) day return window beginning on the date of your purchase on most items.
To receive a 100% refund, items must be returned in New and Original Condition, with all parts, accessories, and original product packaging included.
- Products missing the original packaging or instruction manuals are subject to a 20% restocking fee.
- Products missing parts or accessories are subject to a higher restocking fee.
- Products damaged during use (scratched, chipped, parts broken), disassembled from the original manufacturing or tampered with, are not accepted for returns or refunds. Our return policy does not cover ordinary wear and tear or damage caused by improper use or accidents.
- Microscope slides, coverslips, and eye guards are non-returnable.
- Items marked "Final Sale" are not eligible for return or refund due to change of mind. We are committed to ensuring the quality of all our products. If you receive a final sale item that has an issue, please contact us as soon as possible, and we will resolve any issue on a case by case basis.
When packaging the return, protect the item and original packaging.
- We recommend using the original packaging materials to ensure the product is safe during return shipping.
- If you do not have the original packaging materials, and there is extra room in the box, fill the extra space with padding (paper or shipping peanuts) so the product won't move around during transportation.
Customers are responsible for the return shipping label cost, if the product was not defective.
It can take up to 7 business days for an item to reach us once you ship it. Once we receive the item, it takes 5-7 business days to process the return and refund.
If you have any questions, please an email us at sales@bolioptics.com
Key Features
Specimen are secured in place and protected with a glass cover slip. Brand new slides are passed through quality control inspections for clean, scratch-free and uncontaminated slides.Slides are organized in numerical order. The indexed guide makes it easy to return slides in their places. The plastic box provides easy storage.
Standard sized slides will fit common compound biological microscopes.
Slide Specimens Set Includes:
1. Paramecium (Whole Mount)
2. Honey Bee Wing (Whole Mount)
3. Frog Blood (Smear)
4. Onion Epidermis
5. Tilia Stem (Cross Section)
Technical Specifications
| Glass Slide Application | Microscope Slide |
| Glass Slide Type | Plane Slide |
| Glass Slide Thickness | 1mm |
| Glass Slide Quantity per Pack | 5pc |
| Glass Slide Dimensions | 25.4x76.2mm (1x3 in. ) |
| Cover Slip Shape | Round |
| Cover Slip Dimensions | Dia. 16mm |
| Cover Slip Thickness | 0.15mm |
| Material | Soda Lime Glass |
| Color | Clear |
| Net Weight | 0.034kg (0.075lbs) |
Warranty
No Warranty
Certification
| Packing | |
| Packaging Type | Plastic Box |
| Packaging Material | Plastic |
| Packaging Dimensions(1) | 8.2x3.0x1.8cm (3.228x1.181x0.708″) |
| Gross Weight | 0.25kg (0.55lbs) |
| Minimum Packaging Quantity | 1pc |
| Transportation Carton | Plastic Box |
| Transportation Carton Material | Plastic |
| Transportation Carton Dimensions(1) | 8.2x3.0x1.8cm (3.228x1.181x0.708″) |
| Total Gross Weight of Transportation(kilogram) | 0.25 |
| Total Gross Weight of Transportation(pound) | 0.55 |
| Quantity of One Transportation Carton | 1pc |